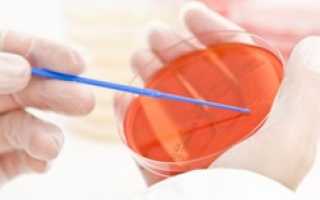

Уреаплазмоз — инфекционное заболевание, вызванное бактериями рода Ureaplasma, поражающее мочеполовую систему мужчин и женщин. Многие носители инфекции не имеют симптомов, но уреаплазмоз может вызвать серьезные осложнения, такие как воспалительные процессы и бесплодие. В статье рассмотрим основные симптомы, методы диагностики и лечения, а также меры профилактики для предотвращения заражения и сохранения здоровья.
Возбудитель и причины уреаплазмоза
Возбудителем уреаплазмоза является микроорганизм Ureaplasma urealyticum (уреаплазма уреалитикум), который относится к семейству Micoplasmataceae и выделяется своим минимальным размером среди известных бактерий. Современные специалисты подчеркивают, что присутствие уреаплазмы в микрофлоре может считаться нормальным. Без определенных факторов она не вызывает патологических изменений.
У 80% женщин, ведущих активную половую жизнь, может быть выявлен уреаплазмоз, тогда как среди мужчин этот показатель значительно ниже. Однако стоит отметить, что у мужчин заболевание часто диагностируется с трудностями, что способствует его распространению. Известны случаи, когда только женщина проходила лечение, так как у мужчины анализы показывали отрицательный результат, но вскоре женщина вновь заражалась.
Уреаплазмой уреалитикум можно заразиться половым путем, а также вертикально — от матери к ребенку. К факторам, способствующим развитию заболевания, относятся:
- активная половая жизнь;
- частая смена партнеров без применения барьерных методов контрацепции;
- стрессовые ситуации;
- ослабленный иммунитет;
- гинекологические заболевания и другие.
Кроме того, прием некоторых медикаментов, например, антибиотиков, может снизить иммунный ответ организма, что приводит к увеличению патогенной микрофлоры.
Врачи отмечают, что уреаплазмоз часто протекает без выраженных симптомов, что затрудняет его раннюю диагностику. Тем не менее, возможные проявления включают жжение при мочеиспускании, выделения из половых органов и боли в области живота. Специалисты подчеркивают важность своевременного обращения к врачу при появлении любых из этих симптомов. Лечение обычно включает антибиотики, однако выбор препарата зависит от индивидуальных особенностей пациента и чувствительности микроорганизмов. Врачи также акцентируют внимание на необходимости лечения обоих партнеров для предотвращения повторного заражения. Профилактика включает использование барьерных методов контрацепции и регулярные медицинские осмотры, что помогает снизить риск передачи инфекции.
Эксперты в области инфекционных заболеваний подчеркивают, что уреаплазмоз может проявляться различными симптомами, включая дискомфорт при мочеиспускании, выделения из половых органов и боли внизу живота. Однако у многих пациентов заболевание протекает бессимптомно, что затрудняет его своевременную диагностику. Лечение обычно включает антибиотики, но важно учитывать индивидуальные особенности пациента и возможные сопутствующие инфекции. Профилактика уреаплазмоза заключается в соблюдении правил личной гигиены, безопасных сексуальных практиках и регулярных медицинских осмотрах. Эксперты настоятельно рекомендуют не игнорировать симптомы и обращаться к врачу при первых признаках заболевания, чтобы избежать осложнений и сохранить здоровье.

Признаки и симптомы уреаплазмоза
Уреаплазмоз не обладает специфическими симптомами, которые относятся лишь к данному заболеванию. Все проявления могут быть признаками других болезней, к примеру, эндометрита, уретрита, цистита, инфекционного артрита, менингита, пневмонии и т. д. Человек может и не догадываться о наличии у себя уреаплазмоза.
Инкубационный период
составляет 3-5 недель с момента заражения, по окончании которого у человека начинают появляться симптомы воспалительного процесса мочеполовой системы.
Женщины страдают от прозрачных выделений
из влагалища, легкой боли внизу живота, раздражения, чувства жжения и зуда при мочеиспускании, цистита. Под воздействием уреаплазмоза развиваются воспалительные процессы репродуктивной системы, что негативным образом сказывается на общее состояние организма.
Кроме того, признаками болезни может быть образование камней в почках, а также наличие спаечных процессов в полости матки, эндометрит, менингит и даже пневмония.
Смотри также – причины и лечение уреаплазмы у женщин.
У мужчин симптомы
не сильно отличаются от женских. Появляются мутные выделения из мочеиспускательного канала, зуд и жжение, боли при мочеиспускании. На фоне уреаплазмоза может развиться простатит, а также астеноспермия, так как возбудители болезни негативным образом влияют на подвижность сперматозоидов. Стоит еще раз отметить, что все вышеперечисленные симптомы могут являться признаками других заболеваний.
Смотри также – симптомы и лечение уреаплазмы у мужчин.
| Симптом | Возможное лечение | Профилактика |
|---|---|---|
| Отсутствие симптомов (часто бессимптомное течение) | Антибиотики (тетрациклины, макролиды, фторхинолоны) | Предохранение во время полового акта (презервативы) |
| Уретрит (воспаление уретры): жжение при мочеиспускании, выделения из уретры | Антибиотики (выбор препарата зависит от чувствительности к антибиотикам) | Отказ от случайных половых связей |
| Цервицит (воспаление шейки матки): выделения из влагалища, боль внизу живота | Антибиотики (выбор препарата зависит от чувствительности к антибиотикам) | Регулярные гинекологические осмотры |
| Простатит (воспаление предстательной железы): боль в промежности, затрудненное мочеиспускание | Антибиотики (выбор препарата зависит от чувствительности к антибиотикам) | Здоровый образ жизни, укрепление иммунитета |
| Воспалительные заболевания органов малого таза (ВЗОМТ): боль внизу живота, лихорадка | Антибиотики (широкий спектр действия), возможно хирургическое вмешательство | Своевременное лечение инфекций мочеполовой системы |
| Бесплодие (как осложнение) | Лечение основного заболевания (уреаплазмоза), вспомогательные репродуктивные технологии (ВРТ) | Лечение инфекций мочеполовой системы до планирования беременности |
Интересные факты
Вот несколько интересных фактов о уреаплазмозе:
-
Скрытая инфекция: Уреаплазмоз часто протекает бессимптомно, что делает его трудным для диагностики. Многие люди могут быть носителями инфекции, не подозревая об этом, что увеличивает риск передачи инфекции половым путем.
-
Связь с другими заболеваниями: Уреаплазма может быть связана с развитием различных осложнений, таких как воспалительные заболевания органов малого таза, бесплодие и даже преждевременные роды у беременных женщин. Это подчеркивает важность своевременной диагностики и лечения.
-
Лечение антибиотиками: Уреаплазмоз обычно лечится антибиотиками, однако выбор препарата может зависеть от чувствительности конкретного штамма уреаплазмы. Важно пройти полный курс лечения и следовать рекомендациям врача, чтобы избежать рецидивов и развития устойчивости к антибиотикам.
Профилактика включает в себя использование барьерных методов контрацепции и регулярные медицинские осмотры для раннего выявления инфекций.
https://youtube.com/watch?v=lxZ4-vrvogM
Влияние уреаплазмоза на беременность
В странах Европы и Америки тесты на уреаплазмоз для беременных женщин не являются стандартной практикой, в то время как в современной российской медицине такие исследования проводятся.
Уреаплазмоз — это заболевание, которое развивается только при определенных условиях. Беременность представляет собой стресс для организма, что может временно ослабить иммунную систему. На этом фоне уреаплазмоз может активизироваться. Женщина может начать испытывать разнообразные симптомы, однако, как уже упоминалось, данное заболевание не имеет уникальных признаков, присущих только ему. Бывают ситуации, когда беременная женщина не подозревает о своем состоянии, поэтому крайне важно своевременно проходить все необходимые обследования.
Уреаплазмоз во время беременности представляет опасность не только своими неприятными проявлениями, но и негативным воздействием на плод.
На ранних сроках беременности могут возникнуть угрозы выкидыша или «замершей» беременности. На более поздних сроках существует риск отслойки плаценты и преждевременных родов. В редких случаях инфекция может привести к развитию врожденной или неонатальной пневмонии.
Неонатальная пневмония проявляется у новорожденного в виде воспаления легких в первый месяц жизни. При врожденной пневмонии ребенок уже рождается с заболеванием и нуждается в срочной медицинской помощи.
Уреаплазмоз — это инфекция, вызванная бактериями рода Ureaplasma. Многие люди не подозревают о его существовании, пока не столкнутся с такими симптомами, как жжение при мочеиспускании, выделения из половых органов и дискомфорт в области таза. Часто уреаплазмоз протекает бессимптомно, что делает его особенно опасным. Лечение обычно включает антибиотики, однако важно помнить, что самолечение может привести к серьезным осложнениям. Профилактика включает соблюдение правил личной гигиены, использование барьерных методов контрацепции и регулярные медицинские осмотры. Многие отмечают, что ранняя диагностика и обращение к специалисту помогают избежать серьезных последствий и сохранить здоровье.
Лечение уреаплазмоза
Выявление условно-патогенных возбудителей уреаплазмоза в микрофлоре не должно являться причиной немедленного лечения. Лишь при развитии болезни, когда симптомы становятся отчетливо видны и характерны, необходимо как можно скорее пройти курс лечения.
Для этих целей используют антибактериальную терапию с применением антибиотиков. Нередко оправдано применение иммуностимуляторов и местных бактерицидных средств. Но никакое медикаментозное лечение уреаплазмоза не поможет, если не будет устранена первопричина развития болезни, к примеру, стресс с последующим снижением иммунитета.
К тому же, лечением необходимо заниматься обоим партнерам, чтобы избежать повторного заражения.
Необходимость и срочность лечения уреаплазмоза у беременных определяется врачом на основании общего состояния организма женщины, его иммунного статуса и соотношения риска от болезни и риска от приема антибиотиков. Чаще всего врачи не рискуют назначать беременным антибактериальную терапию до 22 недели, так как она негативным образом влияет на плод.
Поэтому имеет место быть динамическое наблюдение за состоянием больной.

Осложнения
Осложнения, связанные с уреаплазмозом, могут быть весьма серьезными и неприятными. Чаще всего они возникают из-за отсутствия адекватного лечения или неправильной терапии, что приводит к переходу заболевания в хроническую стадию.
У мужчин уреаплазмоз может спровоцировать воспаление предстательной железы, что сопровождается множеством симптомов. Это заболевание негативно сказывается на подвижности сперматозоидов, что может стать причиной одного из видов мужского бесплодия — астеноспермии.
У женщин уреаплазмоз вызывает воспалительные процессы в матке и влагалище, а также может привести к образованию спаек в маточных трубах. Эти изменения могут стать причиной бесплодия и повысить риск осложнений во время беременности, а также различных патологий у плода. У беременных женщин уреаплазмоз может привести к выкидышу, преждевременным родам, отслойке плаценты, ослаблению шейки матки и различным врожденным патологиям, включая пневмонию у новорожденных.
При ослабленной иммунной системе это заболевание может вызвать воспалительные процессы в тканях и суставах, а также привести к образованию камней в почках и развитию пиелонефрита.
Профилактика уреаплазмоза
Как видно из вышесказанного, уреаплазмоз — заболевание, которое отличается обилием проявлений и серьезными осложнениями. Поэтому профилактика данного заболевания очень важна.
Следующие действия помогут избежать заражения уреаплазмозом:
- следует избегать случайных половых связей с малознакомыми партнерами;
- всегда использовать барьерные контрацептивы;
- регулярно обследоваться за ЗППП (заболевания, передающиеся половым путем);
- в случае заражения, необходимо оповестить всех половых партнеров;
- использовать антисептические растворы после полового акта.
Очень важно не заниматься самолечением. Уреаплазмоз не относится к тем заболеваниям, от которых можно навсегда избавиться лишь недолгим приемом каких-нибудь антибиотиков.
Исключительно врач, зная все нюансы течения болезни, может подобрать адекватное лечение, включающее в себя антибактериальную и иммуномодулирующую терапию.
Диагностика уреаплазмоза
Диагностика уреаплазмоза включает в себя несколько этапов, направленных на выявление наличия уреаплазмы в организме пациента. Основной задачей является определение типа микроорганизма, так как уреаплазмы могут быть как патогенными, так и условно-патогенными. Для этого используются различные методы лабораторной диагностики.
Первым шагом в диагностике является сбор анамнеза и клинический осмотр пациента. Врач выясняет наличие симптомов, таких как жжение при мочеиспускании, выделения из половых органов, боли внизу живота и другие. Важно также учитывать половые контакты и наличие сопутствующих заболеваний.
После первичного осмотра назначаются лабораторные исследования. Наиболее распространенные методы диагностики уреаплазмоза включают:
- ПЦР (полимеразная цепная реакция) — это высокочувствительный метод, который позволяет обнаружить ДНК уреаплазмы в образцах биологического материала, таких как моча, мазки из уретры или влагалища. ПЦР-тесты могут выявить даже небольшое количество микроорганизмов.
- Культуральный метод — заключается в посеве образцов на питательные среды для роста уреаплазмы. Этот метод позволяет не только подтвердить наличие инфекции, но и определить ее чувствительность к антибиотикам.
- Иммуноферментный анализ (ИФА) — используется для выявления антител к уреаплазме в крови. Этот метод может быть полезен для оценки иммунного ответа организма на инфекцию.
- Микроскопия — позволяет визуально оценить наличие микроорганизмов в мазках, однако этот метод менее информативен по сравнению с ПЦР и культуральным методом.
Важно отметить, что диагностика уреаплазмоза может быть затруднена из-за бессимптомного течения инфекции у многих пациентов. Поэтому рекомендуется регулярное обследование, особенно для людей с повышенным риском заражения, таких как лица с незащищенными половыми контактами или имеющие хронические заболевания мочеполовой системы.
После получения результатов анализов врач может назначить соответствующее лечение, если уреаплазма будет выявлена в патогенной форме. Важно также учитывать, что уреаплазмоз может сочетаться с другими инфекциями, поэтому комплексный подход к диагностике и лечению является необходимым.
Вопрос-ответ
Какое самое эффективное средство от уреаплазмы?
При уреаплазме назначают Генферон, Гексикон-Д, Виферон, Панавир, Тержинан. После основной терапии врач-гинеколог может назначить суппозитории Гинофлор, Бифидумбактерин, Вагилак. Эти средства окончательно восстановят микрофлору влагалища.
Как вылечить уреаплазму раз и навсегда?
Полностью вылечить болезнь нельзя. Уреаплазмоз – одна из самых распространенных болезней, которая передается половым путем и поражает органы мочеполовой системы.
Советы
СОВЕТ №1
Регулярно проходите медицинские обследования. Уреаплазмоз может протекать бессимптомно, поэтому важно регулярно проверять свое здоровье у врача, особенно если у вас есть рискованные факторы или вы ведете активную половую жизнь.
СОВЕТ №2
Обратите внимание на симптомы. Если вы заметили такие признаки, как жжение при мочеиспускании, выделения из половых органов или дискомфорт, не откладывайте визит к врачу. Раннее выявление инфекции поможет избежать осложнений.
СОВЕТ №3
Соблюдайте правила личной гигиены. Регулярное мытье и использование индивидуальных средств гигиены помогут снизить риск заражения уреаплазмозом и другими инфекциями, передающимися половым путем.
СОВЕТ №4
Используйте барьерные методы контрацепции. Презервативы не только предотвращают нежелательную беременность, но и защищают от инфекций, передающихся половым путем, включая уреаплазмоз.